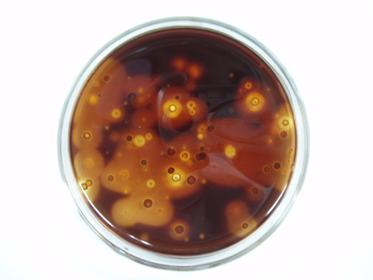
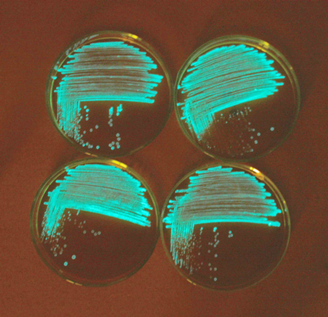
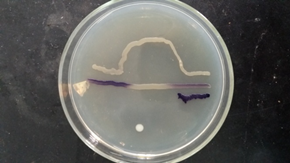
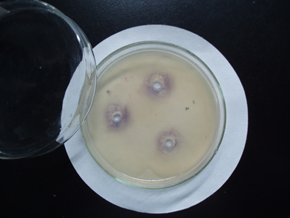
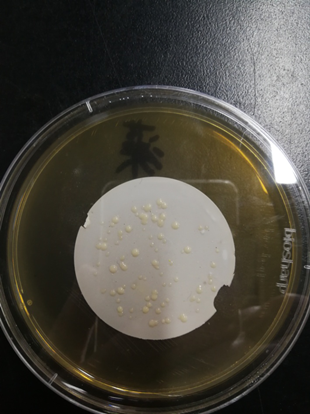
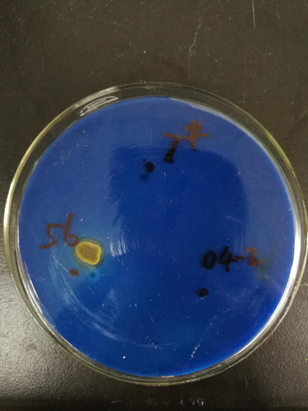
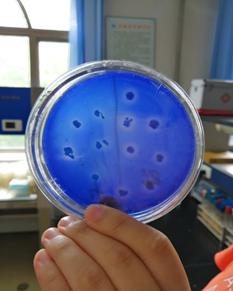
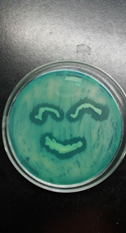
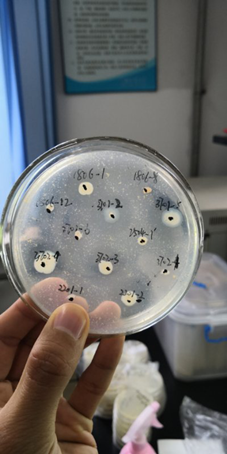

海洋微生物学实验课程简介:
课程名称:海洋微生物学实验
任课教师:王祥红
选课人数:100人/年
学时数:32学时
课程类型:实践(选修)
适用专业:生物科学、生物技术、生态学
海洋微生物学是一门实践性很强的学科,本课程是与海洋微生物学理论教学相配套的实验教学,目的是训练学生掌握海洋微生物学最基本的实验操作技能,了解海洋微生物学的基本知识,加深理解课堂讲授的海洋微生物学理论知识,同时,通过实验培养学生观察、思考、分析问题和解决问题的能力;实事求是,严肃认真的科学态度。实验要求掌握的内容包括海洋细菌和酵母菌的分离培养、计数,海洋细菌的鉴定,海洋细菌的密度感应系统、产淀粉酶海洋酵母的筛选、产琼胶酶细菌的分离及现象观察等。另外,随着分子生物学理论的进展,分子生物学技术和应用也有了显著的改进和发展,已成为生命科学研究的重要工具,培养学生有关分子生物学方面的基本实验技能也至为重要。
本课程目标是为低年级生物科学类学生学习选修的海洋微生物操作技术,引导培养学生用科研思维和微生物技术解决实际问题的能力,提高科学素养。到课程结束时,学生应当能:
1 建立海洋微生物的形态特征概念及分离培养方法。
2 学会分离海洋细菌的实验方法,会筛选具有特殊功能的海洋细菌,并会检测其相对活性。
3 能够分离海洋酵母,并能从中筛选能够产活性物质的海洋酵母菌,检测其活性程度。
4 具有自主设计海洋微生物创新实验的能力。


进行实验
产琼胶酶海洋细菌


发光细菌分离
海洋细菌的发光现象

细菌的群体感应实验
海洋酵母菌落
产丙酮酸海洋酵母
产淀粉酶海洋酵母菌

产嗜杀因子海洋酵母菌
产蛋白酶海洋细菌筛选

细菌鉴定实验
